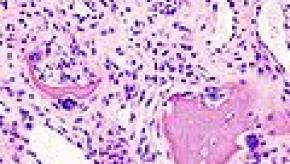
oa.cartilage.jpg

All News
Long term Denosumab Use Shows Favorable Outcomes: Results from the FREEDOM Extension Trial
Osteoporosis is a disease characterized by increased bone loss that outpaces the grown of new bone. As a result bones become less dense and more fragile and brittle; porous bones are more prone to fracture.
Read ArticleDSB: Drug Shortages July 2015
Several drugs continue to be in short supply, posing significant problems for patients. Foremost on this list is leflunomide (Arava) which is backordered for both 10 mg and 20 mg tablets.
Leflunomide Shortage
Read ArticleAllopurinol Risky in Asian Population
The go-to drug to treat hyperuricemia and gout, allopurinol, put patients at risk for developing hypersensitivity when American College of Rheumatology guidelines weren't followed, a large database study found.
Read ArticleRituximab Induced Serum Sickness
Karmacharya and colleages have reviewed 33 cases of rituximab-induced serum sickness. Half of these patients had the classic triad of SS fever, rash, and arthralgia and a self-limiting course. The time to onset after infusion was greater with the first dose of rituximab c
Read ArticleResidents Satisfied and Optimistic
Recently released 2015 Medscape resident salary & debt report shows that most medical residents are satisfied with their compensation, professional relationships, and career choices.
Read ArticleIncreasing Age May Increase Miscarriage Risk in RA
At EULAR 2015, Brouwer and colleagues reported on their cohort of 162 evaluable pregnancies in 239 Dutch women enrolled during 2002-2010 in the nationwide Pregnancy-Induced Amelioration of Rheumatoid Arthritis (PARA) study – a large prospective cohort of pregnant RA patients.
Read ArticleWomen Paid Less as Consultants to Pharma... Again?
Historically, women’s salaries have lagged behind their male colleagues. Women are less likely to achieve leadership roles or be full professors at academic institutions.
Read ArticleDoes Antibiotic Exposure Increase the Risk of JIA?
According to the CDC, between 4300 and 9700 children under the age of 16 are diagnosed with juvenile idiopathic arthritis each year - the cause of which is unknown.
Read ArticleIL-1 Inhibition May Be an Alternative Treatment for Behcet's
Behcet's disease is difficult to manage, especially if the goal is to avoid corticosteroids.
Read ArticleAlpha-1-Anti-Trypsin-Fc Fusion Protein Ameliorates Gouty Arthritis
Gout is the most common inflammatory arthritis affecting adults and, probably, one of the most underestimated.
Read ArticleLithium May Have Chondroprotective Effects in OA
Several studies have suggested that lithium chloride exhibits significant chondroprotective effects on cartilage degradation (in animal models) in response to inflammatory cytokines.
Read ArticleThe Spread of Lyme Disease in the US
It is estimated that Lyme disease affects nearly 30,000 per year in the USA. While it is is still a disorder of the Northeast and upper Midwest, there are more areas also considered to be high risk.
Read ArticleIntracranial Hemorrhage with Combined NSAID and Antidepressant Use
The British Medical Journal reports that the combined use of NSAIDs and anti-depressants were associate with higher rates of intracranial bleeding within 30 days of initiation (Citation source http://buff.ly/1gF3uEJ).
Read ArticleDSB Reports & Updates – July 2015
FDA Scours the Internet for Safety Signals. A Bloomberg News report shows how the FDA is using Google or Yahoo keyword searches to identify new safety signals or drug interactions, often more than a year before they were brought to light by the FDA based on prior methodologies de
Read ArticleTribute to Dr. Norman Talal
The Journal of Clinical Investigation has written a tribute noting the sad passing of Dr. Norman Talal on April 24, 2015.
Dr. Talal was an eminent researcher and clinician known for his research and education on Sjogren’s syndrome.
Read ArticleThe Use of Non-TNF Biologic Treatments in Uveitis Reviewed
A systematic review of treatments used in autoimmune chronic uveitis after failure of DMARDs and at least one TNF inhibitor identified few patients (12 children and 34 adults), and few trials examining rituximab (3), abatacept (3), tocilizumab (3), and 1 each with alemtuzumab and anakin
Read ArticleXeljanz Warnings on Shingles Updated by FDA
The MedWatch June 2015 safety labeling changes were published yesterday, and updated the warnings for Xeljanz (tofacitinib). "The risk of herpes zoster is increased in patients treated with Xeljanz and appears to be higher in patients treated with Xeljanz in Japan."
Read ArticleIRB Conflicts of Interest Persist
Committees at academic institutions that make decisions on research and clinical trials may be conflicted, as nearly one-third of IRB members have some ties to the pharmaceutical industry.
Read Article21st Century Cures Act Passes in the House
On Friday, July 10th, the U.S. House voted overwhelmingly to streamline the approval process of prescription drugs and medical devices by the FDA.
Read ArticlePost-Translationally Modified Proteins as Potential New Early Arthritis Activity Markers
Defects in protein citrullination and its consequences in patients with RA have been studied widely in the recent decade. It appears that autoantibodies, including those against citrullinated proteins, are of diagnostic and prognostic relevance.
Read Article